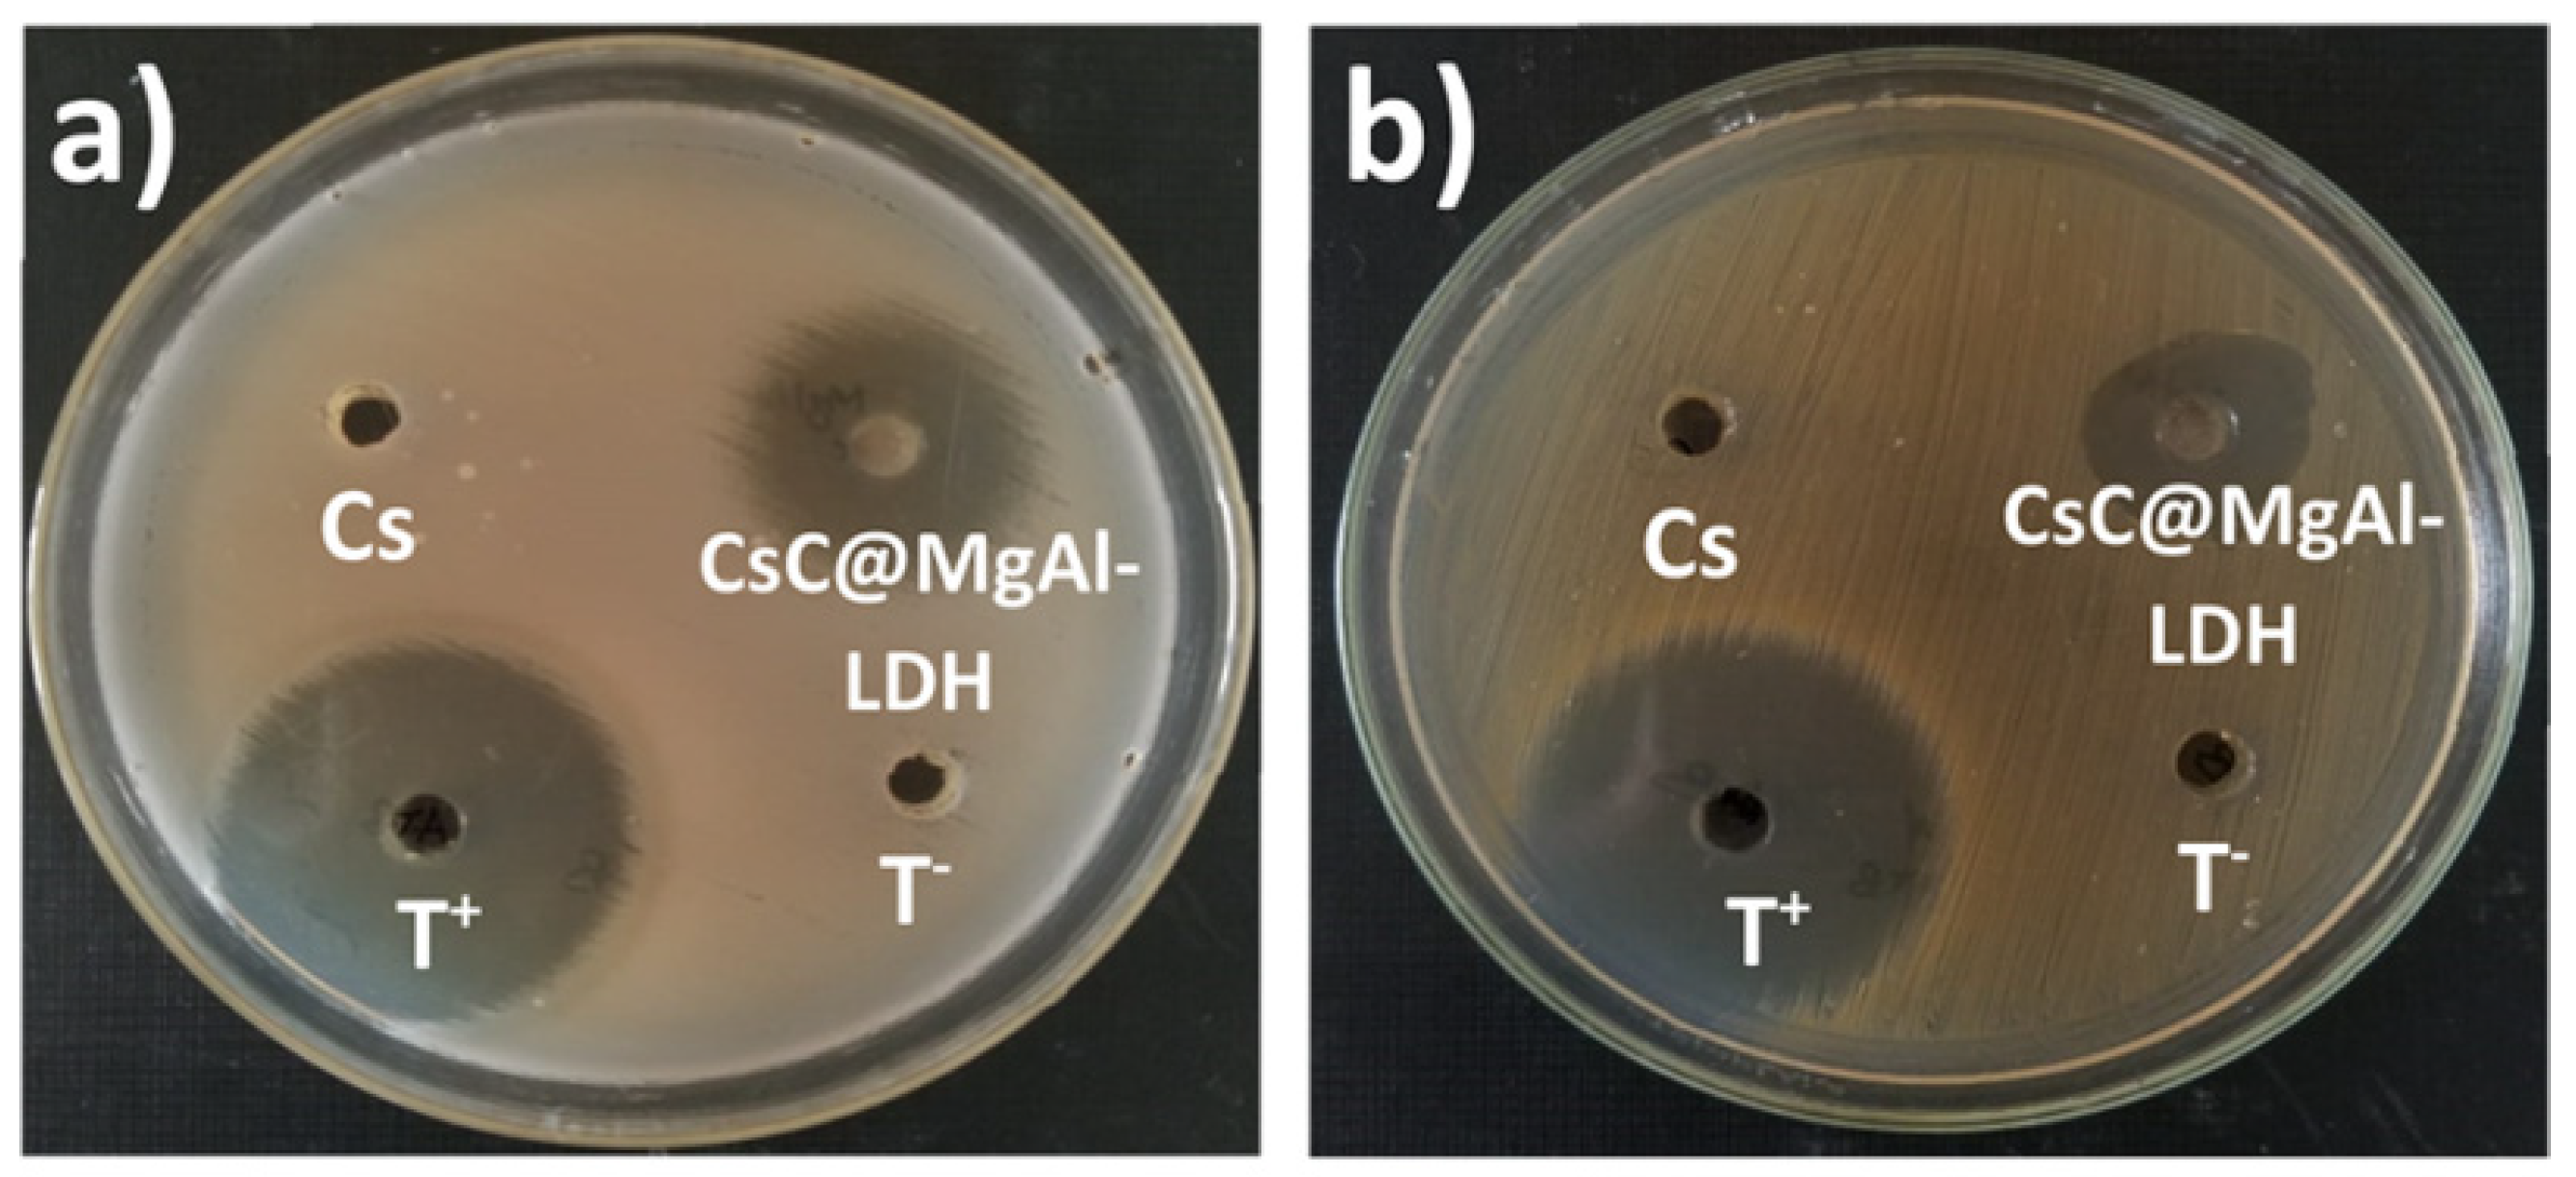
Molecules 29 04406 g022a

Sources and Extraction of Biopolymers and Manufacturing of Bio-Based Nanocomposites for Different Applications
Abstract
1. Introduction
2. Alginate
2.1. Sources and Extraction of Alginate

2.2. Alginate-Based Nanocomposites
3. Pectin
3.1. Source of Pectin
3.2. Methods for Pectin Extraction
3.3. Pectin-Based Bio-Nanocomposites for Diverse Applications
4. Chitin and Chitosan
4.1. Source and Extraction Techniques of Chitin and Chitosan
4.2. Chitosan-Based Bio-Nanocomposites
| Materials | Filler | Properties | Application | Ref |
|---|---|---|---|---|
| Sunflower oil, chitosan, and fly ash | Sunflower oil (2% (w/v)) | Antibacterial activity by agar diffusion method could be done in two possible mechanisms: generation of ROS or electrostatic interaction among the nanocomposite and cell membrane. | Packaging | Alterary et al. [109] |
| Chitosan, Mg/Al LDH | Chitosan:LDH ratio was 3:1 | The surface area of chitosan@MgAl-LDH was 318.26 m2g−1. The prepared bio-nanocomposite was exposed to up to 69.29 mgg−1 adsorption capacity for As(V) removal. | Water treatment | Billah et al. [111] |
| ZnO/chitosan | - | This nanocomposite showed good photodegradation performance for methylene blue (99.2% photodegradation, T = 25 °C, 120 min at pH 8) | Water treatment | Usman et al. [112] |
| Chitosan/ZnO | - | Water treatment | Amirmahani et al. [113] |
5. Starch
5.1. Source and Extraction Techniques of Starch
5.2. Preparation of Starch-Based Nanocomposites
6. Cellulose
6.1. Source and Extraction Techniques of Cellulose
6.2. Preparation of Nanocomposites Based on Cellulose
7. Conclusions and Prospects
Funding
Data Availability Statement
Conflicts of Interest
References
- Jayakumar, A.; Radoor, S.; Kim, J.T.; Rhim, J.W.; Nandi, D.; Parameswaranpillai, J.; Siengchin, S. Recent Innovations in Bionanocomposites-Based Food Packaging Films—A Comprehensive Review. Food Packag. Shelf Life 2022, 33. [Google Scholar] [CrossRef]
- Ali, A.; Bairagi, S.; Ganie, S.A.; Ahmed, S. Polysaccharides and Proteins Based Bionanocomposites as Smart Packaging Materials: From Fabrication to Food Packaging Applications a Review. Int. J. Biol. Macromol. 2023, 252, 126534. [Google Scholar] [CrossRef] [PubMed]
- Chkirida, S.; Zari, N.; Bouhfid, R.; el kacem Qaiss, A. Insight into the Bionanocomposite Applications on Wastewater Decontamination: Review. J. Water Process Eng. 2021, 43, 102198. [Google Scholar] [CrossRef]
- Jaya, B.; Brajesh, B.; Antonella, F.; Giovanna, L.D.; Amit, K. Biopolymer: A Sustainable Material for Food and Medical Applications. Polymers 2022, 14, 983. [Google Scholar] [CrossRef] [PubMed]
- Chakraborty, I.; Sen, I.K.; Mondal, S.; Rout, D.; Bhanja, S.K.; Maity, G.N.; Maity, P. Bioactive Polysaccharides from Natural Sources: A Review on the Antitumor and Immunomodulating Activities. Biocatal. Agric. Biotechnol. 2019, 22, 101425. [Google Scholar] [CrossRef]
- Girish, Y.R.; Kumar, K.S.S.; Prashantha, K.; Rangappa, S.; Sudhanva, M.S. Materials Chemistry Horizons Significance of Antioxidants and Methods to Evaluate Their Potency. Mater. Chem. Horiz. 2023, 2, 93–112. [Google Scholar]
- Heidari, G.; Hassanpour, M.; Nejaddehbashi, F.; Sarfjoo, M.R. Materials Chemistry Horizons REVIEW Biosynthesized Nanomaterials with Antioxidant and Antimicrobial Properties. Mater. Chem. Horiz. 2022, 1, 35–48. [Google Scholar]
- Dinari, M.; Dadkhah, F. Swift Reduction of 4-Nitrophenol by Easy Recoverable Magnetite-Ag/Layered Double Hydroxide/Starch Bionanocomposite. Carbohydr. Polym. 2020, 228, 115392. [Google Scholar] [CrossRef]
- Rezaie, M.; Dinari, M.; Chermahini, A.N.; Saraji, M.; Shahvar, A. Preparation of Kapa Carrageenan-Based Acidic Heterogeneous Catalyst for Conversion of Sugars to High-Value Added Materials. Int. J. Biol. Macromol. 2020, 165, 1129–1138. [Google Scholar] [CrossRef]
- Shabani, S.; Dinari, M. Itaconic Acid-Modified Layered Double Hydroxide/Gellan Gum Nanocomposites for Congo Red Adsorption. Sci. Rep. 2022, 12, 4356. [Google Scholar] [CrossRef]
- Shahzamani, M.; Taheri, S.; Roghanizad, A.; Naseri, N.; Dinari, M. Preparation and Characterization of Hydrogel Nanocomposite Based on Nanocellulose and Acrylic Acid in the Presence of Urea. Int. J. Biol. Macromol. 2020, 147, 187–193. [Google Scholar] [CrossRef] [PubMed]
- Gan, L.; Wang, J.; Guo, Y. Polysaccharides Influence Human Health via Microbiota-Dependent and -Independent Pathways. Front. Nutr. 2022, 9, 1030063. [Google Scholar] [CrossRef] [PubMed]
- Biglari, N. Materials Chemistry Horizons Application of Polysaccharide-Based Materials in Food Packaging. Mater. Chem. Horiz. 2023, 2, 249–268. [Google Scholar]
- Tardy, B.L.; Richardson, J.J.; Greca, L.G.; Guo, J.; Bras, J.; Rojas, O.J. Advancing Bio-Based Materials for Sustainable Solutions to Food Packaging. Nat. Sustain. 2023, 6, 360–367. [Google Scholar] [CrossRef]
- Mohammed, A.S.A.; Naveed, M.; Jost, N. Polysaccharides; Classification, Chemical Properties, and Future Perspective Applications in Fields of Pharmacology and Biological Medicine (A Review of Current Applications and Upcoming Potentialities). J. Polym. Environ. 2021, 29, 2359–2371. [Google Scholar] [CrossRef] [PubMed]
- Flórez-Fernández, N.; Domínguez, H.; Torres, M.D. A Green Approach for Alginate Extraction from Sargassum Muticum Brown Seaweed Using Ultrasound-Assisted Technique. Int. J. Biol. Macromol. 2019, 124, 451–459. [Google Scholar] [CrossRef]
- Benslima, A.; Sellimi, S.; Hamdi, M.; Nasri, R.; Jridi, M.; Cot, D.; Li, S.; Nasri, M.; Zouari, N. The Brown Seaweed Cystoseira Schiffneri as a Source of Sodium Alginate: Chemical and Structural Characterization, and Antioxidant Activities. Food Biosci. 2021, 40, 100873. [Google Scholar] [CrossRef]
- Kaya, M.; Baran, T.; Asan-Ozusaglam, M.; Cakmak, Y.S.; Tozak, K.O.; Mol, A.; Mentes, A.; Sezen, G. Extraction and Characterization of Chitin and Chitosan with Antimicrobial and Antioxidant Activities from Cosmopolitan Orthoptera Species (Insecta). Biotechnol. Bioprocess Eng. 2015, 20, 168–179. [Google Scholar] [CrossRef]
- Uğurlu, E.; Duysak, Ö. A Study on the Extraction of Chitin and Chitosan from the Invasive Sea Urchin Diadema Setosum from Iskenderun Bay in the Northeastern Mediterranean. Environ. Sci. Pollut. Res. 2023, 30, 21416–21424. [Google Scholar] [CrossRef]
- Tissera, W.M.J.C.M.; Rathnayake, S.I.; Abeyrathne, E.D.N.S.; Nam, K.C. An Improved Extraction and Purification Method for Obtaining High-Quality Chitin and Chitosan from Blue Swimmer (Portunus pelagicus) Crab Shell Waste. Food Sci. Biotechnol. 2021, 30, 1645–1655. [Google Scholar] [CrossRef]
- Spinei, M.; Oroian, M. Microwave-Assisted Extraction of Pectin from Grape Pomace. Sci. Rep. 2022, 12, 12722. [Google Scholar] [CrossRef] [PubMed]
- Liew, S.Q.; Chin, N.L.; Yusof, Y.A. Extraction and Characterization of Pectin from Passion Fruit Peels. Agric. Agric. Sci. Procedia 2014, 2, 231–236. [Google Scholar] [CrossRef]
- Darder, M.; Aranda, P.; Ruiz-Hitzky, E. Bionanocomposites: A New Concept of Ecological, Bioinspired, and Functional Hybrid Materials. Adv. Mater. 2007, 19, 1309–1319. [Google Scholar] [CrossRef]
- Zheng, Y.; Monty, J.; Linhardt, R.J. Polysaccharide-Based Nanocomposites and Their Applications. Physiol. Behav. 2017, 176, 139–148. [Google Scholar] [CrossRef] [PubMed]
- Balart, R.; Garcia-Garcia, D.; Fombuena, V.; Quiles-Carrillo, L.; Arrieta, M.P. Biopolymers from Natural Resources. Polymers 2021, 13, 2532. [Google Scholar] [CrossRef]
- Salehi, T.; Shirvani, M.; Dinari, M.; Gavili, E. Adsorptive Removal of Lead from Water Using a Novel Cysteine-Bentonite/Poly(Vinyl Alcohol)/Alginate Nanocomposite. J. Polym. Environ. 2022, 30, 4463–4478. [Google Scholar] [CrossRef]
- Tabibi, A.; Dinari, M.; Afshari, M. κ-Carrageenan/Triazin-Based Covalent Organic Framework Bionanocomposite: Preparation, Characterization, and Its Application in Fast Removing of BB41 Dye from Aqueous Solution. J. Environ. Manag. 2023, 333, 117400. [Google Scholar] [CrossRef]
- Mallakpour, S.; Azadi, E.; Dinari, M. Novel Mesoporous Cupric Oxide-Based Biomaterial: An Efficient Nanocatalyst toward Catalytic Reduction of Emerging Contaminants in the Wastewater. J. Clean. Prod. 2022, 378, 134527. [Google Scholar] [CrossRef]
- Mallakpour, S.; Azadi, E.; Dinari, M. Removal of Cationic and Anionic Dyes Using Ca-Alginate and Zn-Al Layered Double Hydroxide/Metal-Organic Framework. Carbohydr. Polym. 2023, 301, 120362. [Google Scholar] [CrossRef]
- Mallakpour, S.; Azadi, E.; Dinari, M. Mesoporous Ca-Alginate / Melamine-Rich Covalent Organic Polymer / Cupric Oxide-Based Microgel Beads as Heterogeneous Catalyst for Efficient Catalytic Reduction of Hazardous Water Pollutants. J. Environ. Chem. Eng. 2023, 11, 109294. [Google Scholar] [CrossRef]
- Mahardika, M.; Abral, H.; Kasim, A.; Arief, S.; Hafizulhaq, F.; Asrofi, M. Properties of Cellulose Nanofiber/Bengkoang Starch Bionanocomposites: Effect of Fiber Loading. LWT 2019, 116, 108554. [Google Scholar] [CrossRef]
- Gopi, S.; Amalraj, A.; Jude, S.; Thomas, S.; Guo, Q. Bionanocomposite Films Based on Potato, Tapioca Starch and Chitosan Reinforced with Cellulose Nanofiber Isolated from Turmeric Spent. J. Taiwan Inst. Chem. Eng. 2019, 96, 664–671. [Google Scholar] [CrossRef]
- Gharibzahedi, S.M.T.; Ahmadigol, A.; Khubber, S.; Altintas, Z. Bionanocomposite Films with Plasticized WPI-Jujube Polysaccharide/Starch Nanocrystal Blends for Packaging Fresh-Cut Carrots. Food Packag. Shelf Life 2023, 36, 101042. [Google Scholar] [CrossRef]
- Khorasani, A.C.; Shojaosadati, S.A. Bacterial Nanocellulose-Pectin Bionanocomposites as Prebiotics against Drying and Gastrointestinal Condition. Int. J. Biol. Macromol. 2016, 83, 9–18. [Google Scholar] [CrossRef]
- Govindaraj, D.; Rajan, M.; Hatamleh, A.A.; Munusamy, M.A. From Waste to High-Value Product: Jackfruit Peel Derived Pectin/Apatite Bionanocomposites for Bone Healing Applications. Int. J. Biol. Macromol. 2018, 106, 293–301. [Google Scholar] [CrossRef]
- Satriaji, K.P.; Garcia, C.V.; Kim, G.H.; Shin, G.H.; Kim, J.T. Antibacterial Bionanocomposite Films Based on CaSO4-Crosslinked Alginate and Zinc Oxide Nanoparticles. Food Packag. Shelf Life 2020, 24, 100510. [Google Scholar] [CrossRef]
- Ahmad, R.; Ansari, K. Fabrication of Alginate@silver Nanoparticles (Alg@AgNPs) Bionanocomposite for the Sequestration of Crystal Violet Dye from Aqueous Solution. Int. J. Biol. Macromol. 2022, 218, 157–167. [Google Scholar] [CrossRef]
- Wei, Y.; Zou, R.; Xia, Y.; Wang, Z.; Yang, W.; Luo, J.; Liu, C. Enhanced Arsenite Adsorption from Water by Activated MOF Embedded in Macroporous Chitosan Bionanocomposite Beads. Mater. Today Chem. 2022, 26, 101091. [Google Scholar] [CrossRef]
- Narmatha Christy, P.; Khaleel Basha, S.; Sugantha Kumari, V. Multifunctional Organic and Inorganic Hybrid Bionanocomposite of Chitosan/Poly(Vinyl Alcohol)/Nanobioactive Glass/Nanocellulose for Bone Tissue Engineering. J. Mech. Behav. Biomed. Mater. 2022, 135, 105427. [Google Scholar] [CrossRef]
- Hurtado, A.; Aljabali, A.A.A.; Mishra, V.; Tambuwala, M.M.; Serrano-Aroca, Á. Alginate: Enhancement Strategies for Advanced Applications. Int. J. Mol. Sci. 2022, 23, 4486. [Google Scholar] [CrossRef]
- Frent, O.D.; Vicas, L.G.; Duteanu, N.; Morgovan, C.M.; Jurca, T.; Pallag, A.; Muresan, M.E.; Filip, S.M.; Lucaciu, R.L.; Marian, E. Sodium Alginate—Natural Microencapsulation Material of Polymeric Microparticles. Int. J. Mol. Sci. 2022, 23, 12108. [Google Scholar] [CrossRef] [PubMed]
- Ahmad, A.; Mubarak, N.M.; Jannat, F.T.; Ashfaq, T.; Santulli, C.; Rizwan, M.; Najda, A.; Bin-Jumah, M.; Abdel-Daim, M.M.; Hussain, S.; et al. A Critical Review on the Synthesis of Natural Sodium Alginate Based Composite Materials: An Innovative Biological Polymer for Biomedical Delivery Applications. Processes 2021, 9, 137. [Google Scholar] [CrossRef]
- Abasalizadeh, F.; Moghaddam, S.V.; Alizadeh, E.; Akbari, E.; Kashani, E.; Fazljou, S.M.B.; Torbati, M.; Akbarzadeh, A. Alginate-Based Hydrogels as Drug Delivery Vehicles in Cancer Treatment and Their Applications in Wound Dressing and 3D Bioprinting. J. Biol. Eng. 2020, 14, 8. [Google Scholar] [CrossRef]
- Bojorges, H.; López-Rubio, A.; Martínez-Abad, A.; Fabra, M.J. Overview of Alginate Extraction Processes: Impact on Alginate Molecular Structure and Techno-Functional Properties. Trends Food Sci. Technol. 2023, 140, 104142. [Google Scholar] [CrossRef]
- Mallakpour, S.; Azadi, E.; Hussain, C.M. State-of-the-Art of 3D Printing Technology of Alginate-Based Hydrogels—An Emerging Technique for Industrial Applications. Adv. Colloid Interface Sci. 2021, 293, 102436. [Google Scholar] [CrossRef]
- Mallakpour, S.; Azadi, E.; Hussain, C.M. Protection, Disinfection, and Immunization for Healthcare during the COVID-19 Pandemic: Role of Natural and Synthetic Macromolecules. Sci. Total Environ. 2021, 776, 145989. [Google Scholar] [CrossRef]
- Mallakpour, S.; Azadi, E.; Hussain, C.M. Chitosan, Alginate, Hyaluronic Acid, Gums, and β-Glucan as Potent Adjuvants and Vaccine Delivery Systems for Viral Threats Including SARS-CoV-2: A Review. Int. J. Biol. Macromol. 2021, 182, 1931–1940. [Google Scholar] [CrossRef]
- Azucena Castro-Yobal, M.; Contreras-Oliva, A.; Saucedo-Rivalcoba, V.; Rivera-Armenta, J.L.; Hernández-Ramírez, G.; Salinas-Ruiz, J.; Herrera-Corredor, A. Evaluation of Physicochemical Properties of Film-Based Alginate for Food Packing Applications. E-Polymers 2021, 21, 82–95. [Google Scholar] [CrossRef]
- Hasnain, M.S.; Jameel, E.; Mohanta, B.; Dhara, A.K.; Alkahtani, S.; Nayak, A.K. Alginates: Sources, Structure, and Properties. In Alginates in Drug Delivery; Academic Press: Cambridge, MA, USA, 2020; ISBN 9780128176405. [Google Scholar]
- Da Silva, T.L.; Vidart, J.M.M.; da Silva, M.G.C.; Gimenes, M.L.; Vieira, M.G.A. Alginate and Sericin: Environmental and Pharmaceutical Applications. Intech 2010, 34, 57–67. [Google Scholar]
- Draget, K.I.; Nordga, C.T. Alginates. In Handbook of Hydrocolloids; Woodhead Publishing: Sawston, UK, 2021; pp. 805–829. [Google Scholar] [CrossRef]
- Sugiono, S.; Masruri, M.; Estiasih, T.; Widjanarko, S.B. Optimization of Extrusion-Assisted Extraction Parameters and Characterization of Alginate from Brown Algae (Sargassum Cristaefolium). J. Food Sci. Technol. 2019, 56, 3687–3696. [Google Scholar] [CrossRef]
- Mohammed, A.; Rivers, A.; Stuckey, D.C.; Ward, K. Datasets on the Optimization of Alginate Extraction from Sargassum Biomass Using Response Surface Methodology. Data Br. 2020, 31, 105837. [Google Scholar] [CrossRef] [PubMed]
- Mohammed, A.; Rivers, A.; Stuckey, D.C.; Ward, K. Alginate Extraction from Sargassum Seaweed in the Caribbean Region: Optimization Using Response Surface Methodology. Carbohydr. Polym. 2020, 245, 116419. [Google Scholar] [CrossRef] [PubMed]
- Artemisia, R.; Nugroho, A.K.; Setyowati, E.P.; Martien, R. The Properties of Brown Marine Algae Sargassum Turbinarioides and Sargassum Ilicifolium Collected From Yogyakarta, Indonesia. Indones. J. Pharm. 2019, 30, 43. [Google Scholar] [CrossRef]
- Peteiro, C. Alginate Production from Marine Macroalgae, with Emphasis on Kelp Farming. In Alginates and Their Biomedical Applications; Springer: Singapore, 2018; Volume 11, ISBN 9789811069109. [Google Scholar]
- Borazjani, N.J.; Tabarsa, M.; You, S.G.; Rezaei, M. Effects of Extraction Methods on Molecular Characteristics, Antioxidant Properties and Immunomodulation of Alginates from Sargassum Angustifolium. Int. J. Biol. Macromol. 2017, 101, 703–711. [Google Scholar] [CrossRef]
- Silva, M.P.; Jahan, I.; Tonon, T.; Rahatekar, S.; Gomez, D. Environmentally Benign Alginate Extraction and Fibres Spinning from Different European Brown Algae Species. Int. J. Biol. Macromol. 2023, 226, 434–442. [Google Scholar] [CrossRef]
- Nøkling-Eide, K.; Langeng, A.M.; Åslund, A.; Aachmann, F.L.; Sletta, H.; Arlov, Ø. An Assessment of Physical and Chemical Conditions in Alginate Extraction from Two Cultivated Brown Algal Species in Norway: Alaria Esculenta and Saccharina Latissima. Algal Res. 2023, 69, 102951. [Google Scholar] [CrossRef]
- Nøkling-Eide, K.; Tan, F.; Wang, S.; Zhou, Q.; Gravdahl, M.; Langeng, A.M.; Bulone, V.; Aachmann, F.L.; Sletta, H.; Arlov, Ø. Acid Preservation of Cultivated Brown Algae Saccharina Latissima and Alaria Esculenta and Characterization of Extracted Alginate and Cellulose. Algal Res. 2023, 71, 103057. [Google Scholar] [CrossRef]
- Rashedy, S.H.; Abd El Hafez, M.S.M.; Dar, M.A.; Cotas, J.; Pereira, L. Evaluation and Characterization of Alginate Extracted from Brown Seaweed Collected in the Red Sea. Appl. Sci. 2021, 11, 6290. [Google Scholar] [CrossRef]
- Wang, M.; Nian, L.; Wu, J.; Cheng, S.; Yang, Z.; Cao, C. Visible Light-Responsive Chitosan/Sodium Alginate/QDs@ZIF-8 Nanocomposite Films with Antibacterial and Ethylene Scavenging Performance for Kiwifruit Preservation. Food Hydrocoll. 2023, 145, 109073. [Google Scholar] [CrossRef]
- Hou, T.; Sana, S.S.; Kumbhakar, D.V.; Li, H.; Boya, V.K.N.; Aly Saad Aly, M.; Zhang, Z.; Pham, T.D. Synthesis of Sodium-Alginate Capped Silver Nanocomposite Microgel Beads via Bio-Reduction Featuring Multifunctional Antibacterial and Apoptotic Properties in Human Prostate Cancer. J. Drug Deliv. Sci. Technol. 2023, 87, 104799. [Google Scholar] [CrossRef]
- Satheesh Kumar, K.V.; Bindu, M.; Suresh, S.; Anil, A.; Sujoy, S.; Mohanan, A.; Periyat, P. Investigation on Swelling Behavior of Sodium Alginate/Black Titania Nanocomposite Hydrogels and Effect of Synthesis Conditions on Water Uptake. Results Eng. 2023, 20, 101460. [Google Scholar] [CrossRef]
- Tripathy, T.; Saren, R.K.; Banerjee, S.; Senapati, S. Copper Oxide Nanocomposite Particles Supported on Sodium Alginate-g-Polyallylamine Based Reduced Graphene Oxide: An Efficient Electrochemical Sensor for Sensitive Detection of Cadmium Ions in Water. Mater. Chem. Phys. 2023, 305, 127995. [Google Scholar] [CrossRef]
- Roy, S.; Priyadarshi, R.; Łopusiewicz, L.; Biswas, D.; Chandel, V.; Rhim, J.W. Recent Progress in Pectin Extraction, Characterization, and Pectin-Based Films for Active Food Packaging Applications: A Review. Int. J. Biol. Macromol. 2023, 239, 124248. [Google Scholar] [CrossRef] [PubMed]
- Singhal, S.; Swami Hulle, N.R. Citrus Pectins: Structural Properties, Extraction Methods, Modifications and Applications in Food Systems—A Review. Appl. Food Res. 2022, 2, 100215. [Google Scholar] [CrossRef]
- Sun, R.; Niu, Y.; Li, M.; Liu, Y.; Wang, K.; Gao, Z.; Wang, Z.; Yue, T.; Yuan, Y. Emerging Trends in Pectin Functional Processing and Its Fortification for Synbiotics: A Review. Trends Food Sci. Technol. 2023, 134, 80–97. [Google Scholar] [CrossRef]
- Huang, J.; Hu, Z.; Hu, L.; Li, G.; Yao, Q.; Hu, Y. Pectin-Based Active Packaging: A Critical Review on Preparation, Physical Properties and Novel Application in Food Preservation. Trends Food Sci. Technol. 2021, 118, 167–178. [Google Scholar] [CrossRef]
- Mao, Y.; Robinson, J.P.; Binner, E.R. Current Status of Microwave-Assisted Extraction of Pectin. Chem. Eng. J. 2023, 473, 145261. [Google Scholar] [CrossRef]
- Roman-Benn, A.; Contador, C.A.; Li, M.W.; Lam, H.M.; Ah-Hen, K.; Ulloa, P.E.; Ravanal, M.C. Pectin: An Overview of Sources, Extraction and Applications in Food Products, Biomedical, Pharmaceutical and Environmental Issues. Food Chem. Adv. 2023, 2, 100192. [Google Scholar] [CrossRef]
- Liu, Y.; Weng, P.; Liu, Y.; Wu, Z.; Wang, L.; Liu, L. Citrus Pectin Research Advances: Derived as a Biomaterial in the Construction and Applications of Micro/Nano-Delivery Systems. Food Hydrocoll. 2022, 133, 107910. [Google Scholar] [CrossRef]
- Ciriminna, R.; Fidalgo, A.; Scurria, A.; Ilharco, L.M.; Pagliaro, M. Pectin: New Science and Forthcoming Applications of the Most Valued Hydrocolloid. Food Hydrocoll. 2022, 127, 107483. [Google Scholar] [CrossRef]
- Steigerwald, H.; Blanco-Perez, F.; Albrecht, M.; Bender, C.; Wangorsch, A.; Endreß, H.U.; Bunzel, M.; Mayorga, C.; Torres, M.J.; Scheurer, S.; et al. Does the Food Ingredient Pectin Provide a Risk for Patients Allergic to Non-Specific Lipid-Transfer Proteins? Foods 2022, 11, 13. [Google Scholar] [CrossRef] [PubMed]
- Beukema, M.; Faas, M.M.; de Vos, P. The Effects of Different Dietary Fiber Pectin Structures on the Gastrointestinal Immune Barrier: Impact via Gut Microbiota and Direct Effects on Immune Cells. Exp. Mol. Med. 2020, 52, 1364–1376. [Google Scholar] [CrossRef] [PubMed]
- Leclere, L.; Van Cutsem, P.; Michiels, C. Anti-Cancer Activities of PH- or Heat-Modified Pectin. Front. Pharmacol. 2013, 4, 128. [Google Scholar] [CrossRef] [PubMed]
- Liu, J.; Bi, J.; McClements, D.J.; Liu, X.; Yi, J.; Lyu, J.; Zhou, M.; Verkerk, R.; Dekker, M.; Wu, X.; et al. Impacts of Thermal and Non-Thermal Processing on Structure and Functionality of Pectin in Fruit- and Vegetable- Based Products: A Review. Carbohydr. Polym. 2020, 250, 116890. [Google Scholar] [CrossRef] [PubMed]
- Kedir, W.M.; Deresa, E.M.; Diriba, T.F. Pharmaceutical and Drug Delivery Applications of Pectin and Its Modified Nanocomposites. Heliyon 2022, 8, 10654. [Google Scholar] [CrossRef]
- Viscusi, G.; Lamberti, E.; D’amico, F.; Tammaro, L.; Gorrasi, G. Fabrication and Characterization of Bio-Nanocomposites Based on Halloysite-Encapsulating Grapefruit Seed Oil in a Pectin Matrix as a Novel Bio-Coating for Strawberry Protection. Nanomaterials 2022, 12, 1265. [Google Scholar] [CrossRef]
- Suhasini, M.R.; Rajeshwari, K.M.; Bindya, S.; Hemavathi, A.B.; Vishwanath, P.M.; Syed, A.; Eswaramoorthy, R.; Amachawadi, R.G.; Shivamallu, C.; Chattu, V.K.; et al. Pectin/PVA and Pectin-MgO/PVA Films: Preparation, Characterization and Biodegradation Studies. Heliyon 2023, 9, e15792. [Google Scholar] [CrossRef]
- Souza, V.G.L.; Mello, I.P.; Khalid, O.; Pires, J.R.A.; Rodrigues, C.; Alves, M.M.; Santos, C.; Fernando, A.L.; Coelhoso, I. Strategies to Improve the Barrier and Mechanical Properties of Pectin Films for Food Packaging: Comparing Nanocomposites with Bilayers. Coatings 2022, 12, 108. [Google Scholar] [CrossRef]
- Przybyszewska, A.; Barbosa, C.H.; Pires, F.; Pires, J.R.A.; Rodrigues, C.; Galus, S.; Souza, V.G.L.; Alves, M.M.; Santos, C.F.; Coelhoso, I.; et al. Packaging of Fresh Poultry Meat with Innovative and Sustainable ZnO/Pectin Bionanocomposite Films—A Contribution to the Bio and Circular Economy. Coatings 2023, 13, 1208. [Google Scholar] [CrossRef]
- Candido, G.S.; Natarelli, C.V.L.; Carvalho, E.E.N.; Oliveira, J.E. Bionanocomposites of Pectin and Pracaxi Oil Nanoemulsion as Active Packaging for Butter. Food Packag. Shelf Life 2022, 32, 100862. [Google Scholar] [CrossRef]
- Khorasani, A.C.; Kouhfar, F.; Shojaosadati, S.A. Pectin/Lignocellulose Nanofibers/Chitin Nanofibers Bionanocomposite as an Efficient Biosorbent of Cholesterol and Bile Salts. Carbohydr. Polym. 2021, 261, 117883. [Google Scholar] [CrossRef] [PubMed]
- Wang, C.; Li, G.; Karmakar, B.; AlSalem, H.S.; Shati, A.A.; El-kott, A.F.; Elsaid, F.G.; Bani-Fwaz, M.Z.; Alsayegh, A.A.; Salem Alkhayyat, S.; et al. Pectin Mediated Green Synthesis of Fe3O4/Pectin Nanoparticles under Ultrasound Condition as an Anti-Human Colorectal Carcinoma Bionanocomposite. Arab. J. Chem. 2022, 15, 103867. [Google Scholar] [CrossRef]
- Al-arjan, W.S.; Umar, M.; Khan, A.; Nazir, S. Pectin/Graphene Oxide/Nano-Hydroxyapatite Based Nanocomposite Scaff olds with Controlled Release of Drug for Bone Tissue Engineering: In-Vitro Evaluation of Biocompatibility and Cytotoxicity. Coatings 2021, 10, 1120. [Google Scholar] [CrossRef]
- Mohan, K.; Ganesan, A.R.; Ezhilarasi, P.N.; Kondamareddy, K.K.; Rajan, D.K.; Sathishkumar, P.; Rajarajeswaran, J.; Conterno, L. Green and Eco-Friendly Approaches for the Extraction of Chitin and Chitosan: A Review. Carbohydr. Polym. 2022, 287, 119349. [Google Scholar] [CrossRef] [PubMed]
- Hisham, F.; Maziati Akmal, M.H.; Ahmad, F.; Ahmad, K.; Samat, N. Biopolymer Chitosan: Potential Sources, Extraction Methods, and Emerging Applications. Ain Shams Eng. J. 2023, 15, 102424. [Google Scholar] [CrossRef]
- Islam, N.; Hoque, M.; Taharat, S.F. Recent Advances in Extraction of Chitin and Chitosan. World J. Microbiol. Biotechnol. 2023, 39, 28. [Google Scholar] [CrossRef]
- Oladzadabbasabadi, N.; Mohammadi Nafchi, A.; Ariffin, F.; Wijekoon, M.M.J.O.; Al-Hassan, A.A.; Dheyab, M.A.; Ghasemlou, M. Recent Advances in Extraction, Modification, and Application of Chitosan in Packaging Industry. Carbohydr. Polym. 2022, 277, 118876. [Google Scholar] [CrossRef]
- Ilyas, R.A.; Aisyah, H.A.; Nordin, A.H.; Ngadi, N.; Yusoff, M.; Zuhri, M.; Rizal, M.; Asyraf, M.; Sapuan, S.M.; Zainudin, E.S.; et al. Nanocomposites for Various Advanced Applications. Polymers 2022, 14, 874. [Google Scholar] [CrossRef]
- Kou, S.; Peters, L.M.; Mucalo, M.R. Chitosan: A Review of Sources and Preparation Methods. Int. J. Biol. Macromol. 2021, 169, 85–94. [Google Scholar] [CrossRef]
- Mallakpour, S.; Azadi, E.; Hussain, C.M. Chitosan/Carbon Nanotube Hybrids: Recent Progress and Achievements for Industrial Applications. New J. Chem. 2021, 45, 3756–3777. [Google Scholar] [CrossRef]
- Mohan, K.; Karthick Rajan, D.; Rajarajeswaran, J.; Divya, D.; Ramu Ganesan, A. Recent Trends on Chitosan Based Hybrid Materials for Wastewater Treatment: A Review. Curr. Opin. Environ. Sci. Health 2023, 33, 100473. [Google Scholar] [CrossRef]
- Suyambulingam, I.; Gangadhar, L.; Sana, S.S.; Divakaran, D.; Siengchin, S.; Kurup, L.A.; Iyyadurai, J.; Albert Bernad Noble, K.E. Chitosan Biopolymer and Its Nanocomposites: Emerging Material as Adsorbent in Wastewater Treatment. Adv. Mater. Sci. Eng. 2023, 2023, 9387016. [Google Scholar] [CrossRef]
- Abere, D.V.; Ojo, S.A.; Paredes-Epinosa, M.B.; Hakami, A. Derivation of Composites of Chitosan-Nanoparticles from Crustaceans Source for Nanomedicine: A Mini Review. Biomed. Eng. Adv. 2022, 4, 100058. [Google Scholar] [CrossRef]
- Kedir, W.M.; Abdi, G.F.; Goro, M.M.; Tolesa, L.D. Pharmaceutical and Drug Delivery Applications of Chitosan Biopolymer and Its Modified Nanocomposite: A Review. Heliyon 2022, 8, e10196. [Google Scholar] [CrossRef]
- Amari, A.; Alzahrani, F.M.; Katubi, K.M.; Alsaiari, N.S.; Tahoon, M.A.; Rebah, F. Ben Clay-Polymer Nanocomposites: Preparations and Utilization for Pollutants Removal. Materials 2021, 14, 1365. [Google Scholar] [CrossRef]
- Saberi Riseh, R.; Vatankhah, M.; Hassanisaadi, M.; Kennedy, J.F. Chitosan-Based Nanocomposites as Coatings and Packaging Materials for the Postharvest Improvement of Agricultural Product: A Review. Carbohydr. Polym. 2023, 309, 120666. [Google Scholar] [CrossRef]
- Saruchi; Kaur, M.; Kumar, V.; Ghfar, A.A.; Pandey, S. A Green Approach for the Synthesis of Silver Nanoparticle-Embedded Chitosan Bionanocomposite as a Potential Device for the Sustained Release of the Itraconazole Drug and Its Antibacterial Characteristics. Polymers 2022, 14, 1911. [Google Scholar] [CrossRef]
- Regiel-Futyra, A.; Kus-Liśkiewicz, M.; Sebastian, V.; Irusta, S.; Arruebo, M.; Kyzioł, A.; Stochel, G. Development of Noncytotoxic Silver-Chitosan Nanocomposites for Efficient Control of Biofilm Forming Microbes. RSC Adv. 2017, 7, 52398–52413. [Google Scholar] [CrossRef]
- Mahmoud, M.E.; Ibrahim, G.A.A. Cr(VI) and Doxorubicin Adsorptive Capture by a Novel Bionanocomposite of Ti-MOF@TiO2 Incorporated with Watermelon Biochar and Chitosan Hydrogel. Int. J. Biol. Macromol. 2023, 253, 126489. [Google Scholar] [CrossRef]
- Ben Aoun, R.; Trabelsi, N.; Abdallah, M.; Mourtzinos, I.; Mhamdi, R. Towards a Greener Future: Exploring the Challenges of Extraction of Chitin and Chitosan as Bioactive Polysaccharides. Mater. Today Commun. 2024, 39, 108761. [Google Scholar] [CrossRef]
- Huq, T.; Khan, A.; Brown, D.; Dhayagude, N.; He, Z.; Ni, Y. Sources, Production and Commercial Applications of Fungal Chitosan: A Review. J. Bioresour. Bioprod. 2022, 7, 85–98. [Google Scholar] [CrossRef]
- Azmana, M.; Mahmood, S.; Hilles, A.R.; Rahman, A.; Bin Arifin, M.A.; Ahmed, S. A Review on Chitosan and Chitosan-Based Bionanocomposites: Promising Material for Combatting Global Issues and Its Applications. Int. J. Biol. Macromol. 2021, 185, 832–848. [Google Scholar] [CrossRef] [PubMed]
- Hisham, F.; Maziati Akmal, M.H.; Ahmad, F.B.; Ahmad, K. Facile Extraction of Chitin and Chitosan from Shrimp Shell. Mater. Today Proc. 2021, 42, 2369–2373. [Google Scholar] [CrossRef]
- Hongkulsup, C.; Khutoryanskiy, V.V.; Niranjan, K. Enzyme Assisted Extraction of Chitin from Shrimp Shells (Litopenaeus vannamei). J. Chem. Technol. Biotechnol. 2016, 91, 1250–1256. [Google Scholar] [CrossRef]
- Tan, Y.N.; Lee, P.P.; Chen, W.N. Microbial Extraction of Chitin from Seafood Waste Using Sugars Derived from Fruit Waste-Stream. AMB Express 2020, 10, 17. [Google Scholar] [CrossRef] [PubMed]
- Alterary, S.S.; Amina, M.; El-Tohamy, M.F. Biogenic Sunflower Oil-Chitosan Decorated Fly Ash Nanocomposite Film Using White Shrimp Shell Waste: Antibacterial and Immunomodulatory Potential. PLoS ONE 2023, 18, e0282742. [Google Scholar] [CrossRef]
- Rahman, M.M. Waste Biomass Derived Chitosan-Natural Clay Based Bionanocomposites Fabrication and Their Potential Application on Wastewater Purification by Continuous Adsorption: A Critical Review. S. Afr. J. Chem. Eng. 2024, 48, 214–236. [Google Scholar] [CrossRef]
- Billah, R.E.K.; Azoubi, Z.; López-Maldonado, E.A.; Majdoubi, H.; Lgaz, H.; Lima, E.C.; Shekhawat, A.; Tamraoui, Y.; Agunaou, M.; Soufiane, A.; et al. Multifunctional Cross-Linked Shrimp Waste-Derived Chitosan/MgAl-LDH Composite for Removal of As(V) from Wastewater and Antibacterial Activity. ACS Omega 2023, 8, 10051–10061. [Google Scholar] [CrossRef]
- Usman, U.L.; Singh, N.B.; Allam, B.K.; Banerjee, S. Biogenic Synthesis of Zinc Oxide/Chitosan Nanocomposite Using Callistemon Citrinus (Bottle brush) for Photocatalytic Degradation of Methylene Blue. Macromol. Symp. 2023, 407, 2100357. [Google Scholar] [CrossRef]
- Amirmahani, N.; Mahdizadeh, H.; Seyedi, N.; Nasiri, A.; Yazdanpanah, G. Synthesis and Performance Evaluation of Chitosan/Zinc Oxide Nanocomposite as a Highly Efficient Adsorbent in the Removal of Reactive Red 198 from Water. J. Chin. Chem. Soc. 2023, 70, 869–878. [Google Scholar] [CrossRef]
- Kupervaser, M.G.; Traffano-Schiffo, M.V.; Dellamea, M.L.; Flores, S.K.; Sosa, C.A. Trends in Starch-Based Edible Films and Coatings Enriched with Tropical Fruits Extracts: A Review. Food Hydrocoll. Health 2023, 4, 100138. [Google Scholar] [CrossRef]
- Kaur, P.; Kaur, K.; Basha, S.J.; Kennedy, J.F. Current Trends in the Preparation, Characterization and Applications of Oat Starch—A Review. Int. J. Biol. Macromol. 2022, 212, 172–181. [Google Scholar] [CrossRef] [PubMed]
- Salimi, M.; Channab, B.-E.; El Idrissi, A.; Zahouily, M.; Motamedi, E. A Comprehensive Review on Starch: Structure, Modification, and Applications in Slow/Controlled-Release Fertilizers in Agriculture. Carbohy. Polym. 2023, 322, 121326. [Google Scholar] [CrossRef] [PubMed]
- Kringel, D.H.; El Halal, S.L.M.; Zavareze, E.d.R.; Dias, A.R.G. Methods for the Extraction of Roots, Tubers, Pulses, Pseudocereals, and Other Unconventional Starches Sources: A Review. Starch/Staerke 2020, 72, 1900234. [Google Scholar] [CrossRef]
- Kringel, D.H.; Dias, A.R.G.; Zavareze, E.d.R.; Gandra, E.A. Fruit Wastes as Promising Sources of Starch: Extraction, Properties, and Applications. Starch/Staerke 2020, 72, 1900200. [Google Scholar] [CrossRef]
- Mary, S.K.; Koshy, R.R.; Arunima, R.; Thomas, S.; Pothen, L.A. A Review of Recent Advances in Starch-Based Materials: Bionanocomposites, PH Sensitive Films, Aerogels and Carbon Dots. Carbohydr. Polym. Technol. Appl. 2022, 3, 100190. [Google Scholar] [CrossRef]
- Ghoshal, G.; Kaur, M. Optimization of Extraction of Starch from Sweet Potato and Its Application in Making Edible Film. Food Chem. Adv. 2023, 3, 100356. [Google Scholar] [CrossRef]
- Weligama Thuppahige, V.T.; Moghaddam, L.; Welsh, Z.G.; Wang, T.; Xiao, H.W.; Karim, A. Extraction and Characterisation of Starch from Cassava (Manihot esculenta) Agro-Industrial Wastes. LWT 2023, 182, 114787. [Google Scholar] [CrossRef]
- Mieles-g, L.; Quintana, S.E.; Garc, L.A. Kernel Starch: Chemical, Techno-Functional, and Pasting Properties. Gels 2023, 9, 136. [Google Scholar] [CrossRef]
- Arifin, H.R.; Djali, M.; Nurhadi, B.; Azlin-Hasim, S.; Masruchin, N.; Vania, P.A.; Hilmi, A. Corn Starch-Based Bionanocomposite Film Reinforced With ZnO Nanoparticles and Different Types of Plasticizers. Front. Sustain. Food Syst. 2022, 6, 886219. [Google Scholar] [CrossRef]
- Jaiyeola, O.O.; Annath, H.; Mangwandi, C. Synthesis and Evaluation of a New CeO2@starch Nanocomposite Particles for Efficient Removal of Toxic Cr(VI) Ions. Energy Nexus 2023, 12, 100244. [Google Scholar] [CrossRef]
- Chitena, L.; Muiva, C.; Kebaabetswe, L.P. Application of In-Situ Casted ZnO-Starch Nanocomposite for Packaging of Strawberries (Fragaria x ananassa). Heliyon 2023, 9, e22556. [Google Scholar] [CrossRef] [PubMed]
- Jiang, Z.; To, N. Recent Advances in Chemically Modified Cellulose and Its Derivatives for Food Packaging Applications: A Review. Polymers 2022, 14, 1533. [Google Scholar] [CrossRef] [PubMed]
- Chopra, L. Manikanika Extraction of Cellulosic Fibers from the Natural Resources: A Short Review. Mater. Today Proc. 2021, 48, 1265–1270. [Google Scholar] [CrossRef]
- Khairnar, Y.; Hansora, D.; Hazra, C.; Kundu, D.; Tayde, S.; Tonde, S.; Naik, J.; Chatterjee, A. Cellulose Bionanocomposites for Sustainable Planet and People: A Global Snapshot of Preparation, Properties, and Applications. Carbohydr. Polym. Technol. Appl. 2021, 2, 100065. [Google Scholar] [CrossRef]
- Danafar, F. Recent Development and Challenges in Synthesis of Cellulosic Nanostructures and Their Application in Developing Paper-Based Energy Devices. Cellul. Chem. Technol. 2020, 54, 327–346. [Google Scholar] [CrossRef]
- Trache, D.; Tarchoun, A.F.; Derradji, M.; Hamidon, T.S.; Masruchin, N.; Brosse, N.; Hussin, M.H. Nanocellulose: From Fundamentals to Advanced Applications. Front. Chem. 2020, 8, 392. [Google Scholar] [CrossRef]
- Rizwan, M.; Gilani, S.R.; Durrani, A.I.; Naseem, S. Cellulose Extraction of Alstonia Scholaris: A Comparative Study on Efficiency of Different Bleaching Reagents for Its Isolation and Characterization. Int. J. Biol. Macromol. 2021, 191, 964–972. [Google Scholar] [CrossRef]
- Abzan, N.; Abbasian, A.; Jonoobi, M.; Ghasemi, I. Cellulose Microfiber Extraction from Leftover Celery Pulp: Chemomechanical Treatments, Structural, Morphological, and Thermal Characterization. Int. J. Biol. Macromol. 2023, 253, 126834. [Google Scholar] [CrossRef]
- Chen, Z.; Xie, Z.; Jiang, H. Extraction of the Cellulose Nanocrystals via Ammonium Persulfate Oxidation of Beaten Cellulose Fibers. Carbohydr. Polym. 2023, 318, 121129. [Google Scholar] [CrossRef]
- Freixo, R.; Casanova, F.; Ribeiro, A.B.; Pereira, C.F.; Costa, E.M.; Pintado, M.E.; Ramos, Ó.L. Extraction Methods and Characterization of Cellulose Fractions from a Sugarcane By-Product for Potential Industry Applications. Ind. Crops Prod. 2023, 197, 116615. [Google Scholar] [CrossRef]
- Emenike, E.C.; Iwuozor, K.O.; Saliu, O.D.; Ramontja, J.; Adeniyi, A.G. Advances in the Extraction, Classification, Modification, Emerging and Advanced Applications of Crystalline Cellulose: A Review. Carbohydr. Polym. Technol. Appl. 2023, 6, 100337. [Google Scholar] [CrossRef]
- Shi, C.; An, B.; Zhang, L.; Zai, Z.; Shi, Z.; Wang, Z.; Ma, J. Contribution of Surface Carboxyl of Cellulose in the Formation Mechanism and Interfacial Catalysis Activity of ZnO/Cellulose Nanocomposites. Appl. Surf. Sci. 2023, 618, 156633. [Google Scholar] [CrossRef]
- Arularasu, M.V.; Venkatadri, B.; Muthukrishnaraj, A.; Rajendran, T.V.; Qi, K.; Kaviyarasu, K. H2O2 Scavenging and Biocompatibility Assessment of Biosynthesized Cellulose/Fe3O4 Nanocomposite Showed Superior Antioxidant Properties with Increasing Concentration. J. Mol. Struct. 2023, 1289, 135838. [Google Scholar] [CrossRef]
- Hong, Y.; Islam, S.R.; Liang, G.; Tang, X.; Shen, X.; Jiang, J. A Novel Structure of Cellulose-TiO2 Nanocomposite for Ultra-Fast and Recyclable Organic Dyes Degradation in Wastewater. J. Environ. Chem. Eng. 2023, 11, 111236. [Google Scholar] [CrossRef]

| Source | Extraction Method | Yield | Properties | Ref |
|---|---|---|---|---|
| Different European Brown algae species:Saccharina latissima (SAC), Laminaria digitata (LAM), Sacchoriza polyschides (SACC), and Himanthalia spp. (HIM) | Sustainable protocol based on Citric acid | In small scale: 61–65% for SAC and LAM, and 34–41% for SACC and HIM. Scaling-up extraction: 26–30% (30% for SAC, 37% for LAM, 32% for HIM and 26% for SACC). | The ManA/GulA ratios were 1.98 for SAC, 2.23 for LAM, 1.83 for SACC, and 1.86 for HIM and similar to the value obtained for the commercial alginate 1.84). | Silva et al. [58] |
| Alaria esculenta and Saccharina latissima | Alkaline extraction | At optimum condition (pH 9), had a yield of 185 ± 7 and 229 ± 12 mg/g dry-weight seaweed | The purity of the extracted alginates was evaluated based on the content of coextracted impurities and was found to be comparable with high-quality commercial alginates. | Nøkling-Eide et al. [59,60] |
| Brown seaweeds (Padina boergesenii, Turbinaria triquetra, Hormophysa cuneiformis, Dictyota ciliolata, and Sargassum aquifolium) | Alkaline extraction | The highest yield of was from T. triquetra (22.2 ± 0.56% DW), while the lowest content was observed in H. cuneiformis (13.3 ± 0.52% DW). | The alginate extracted from the five selected seaweeds also demonstrated food-grade quality. | Rashedy et al. [61] |
| Materials | Filler | Properties | Application | Ref |
|---|---|---|---|---|
| Na-alginate, chitosan, quantum dots, and metal-organic frameworks (ZIF-8) layer-by-layer (LBL) assembly method | Amount of 0.1%, 0.25%, and 0.5% | Good antibacterial performance (>99%) against foodborne microorganisms under visible light irradiation and >40% ethylene scavenging feature. | Packaging | Wang et al. [62] |
| Ag nanoparticles, alginate | - | Promising antibacterial and anticancer properties. | Medical | Hou et al. [63] |
| Na-alginate/black nano TiO2 | Amount of 0, 0.02, 0.2, and 2% (w/v) | Hydrogel containing 2% (w/v) TiO2 showed the highest dye degradation potential (99% of both methylene blue (by 180 min) and malachite green (by 360 min)). | Water treatment | Kumar et al. [64] |
| Alginate-g-polyallylamine/reduced graphene oxide/CuO | - | In Cd2+ sensing, the limit of quantitation and limit of detection were 4.24 nM and 1.27 nM, respectively. This sensor was stable, and reproducibility was satisfactory. | Water treatment | Tripathy et al. [65] |
| Materials | Filler | Properties | Application | Ref |
|---|---|---|---|---|
| Halloysite nanotubes, grapefruit seed oil, pectin | Different amounts of grapefruit seed oil 20, 30, and 50% w/w) | Increase in water permeability up to 480%, 200%, increase in elastic modulus, and deformation at breaking up to 39%. | Packaging | Viscusi et al. [79] |
| Pectin, poly (vinyl alcohol), MgO | Amount of 0.5 g of pectin and 0.15 g of poly (vinyl alcohol) 2.4 g of Mg(NO3)2⋅6H2O | Bio-nanocomposite film with MgO displayed increased antioxidant activity, low solubility, and decreased water vapor permeability. | Packaging | Suhasini et al. [80] |
| Pectin, cellulose nanocrystals, montmorillonite nanoparticles, and chitosan | Amount of 2.5 wt.% of montmorillonite and cellulose | All pectin-based films showed higher oxygen barrier features than polyethylene. | Packaging | Souza et al. [81] |
| Pectin, ZnO | ZnO nanoparticles (5w/w% relative to pectin), | Bio-nanocomposites presented good antimicrobial and antioxidant. Activity. | Food packaging | Przybyszewska et al. [82] |
| Pectin, pracaxi oil | Pracaxi oil at 0, 0.1, 0.2, 0.3, and 0.4% wt | The antioxidant oil with the presence of phenolic compounds efficiently enhanced the butter stability against oxidation processes during the 60 days of storage. | Food packaging | Candido et al. [83] |
| Pectin/lignocellulose/chitin | Amount of 52%, 31%, and 17%, respectively in 1% (w/v) | The maximum adsorption capacity was 5578.4 mg/g bile salts and 37.9 mg/g cholesterol. | Medicine and food industry | Khorasani et al. [84] |
| Pectin, Fe3O4 | - | The product as an antihuman colorectal carcinoma bio-nanocomposite exhibited high antioxidant activity toward DPPH | Medicine | Wang et al. [85] |
| Apple pectin, arabinoxylan, hydroxyapatite, and graphene oxide | Amount of 0.1, 0.2, 0.3, and 0.4 mg of graphene oxide | Graphene oxide improved physicochemical as well as biomechanical features of composite. | Medicine | Al-Arjan et al. [86] |
| Source | Extraction Method | Yield | Properties | Ref |
|---|---|---|---|---|
| Shrimp shells | Chemical extraction by NaOH, HCl | - | Chitosan with 65% deacetylation degree and with rod-like micro-structure was effectively produced. | Hisham et al. [106] |
| Shrimp shells | Enzymatic methods | Maximum demineralization values were 98.64 and 97.57% for lactic 15 and acetic acids, respectively. | Physicochemical analysis indicated that the enzyme assisted production of chitin seems appropriate to extract chitin, possibly retaining its native structure. | Hongkulsup et al. [107] |
| Seafood waste | Microbial extraction | Potato peel had the highest dry weight of chitin (0.89 g yield). | Red grape pomace resulted in 72.90% deacetylation degree and 95.54% crystallinity degree. | Nian Tan et al. [108] |
| Material | Method | Yield | Properties | Ref |
|---|---|---|---|---|
| Sweet potato, gelatine | Alkali extraction | 27.4–30.1 | The ash and protein contents were low (0.1–0.5(%), and 0.1–0.23(%)), which showed high purity of the product. | Ghoshal et al. [120] |
| Cassava (Manihot esculenta) agro-industrial wastes | Hot-water extraction method | 30 ± 2% wt | Employing cassava peel to extract starch was more effective than that of cassava bagasse. | Thuppahige et al. [121] |
| Mango (Mangifera indica) kernel | Ultrasound-assisted extraction | 54% | A significant increase in the amylose content, water-holding capacity, oil-holding capacity, solubility, and swelling power of ultrasonically extracted starches was observed. | Mieles-Gómez et al. [122] |
| Materials | Filler | Properties | Application | Ref |
|---|---|---|---|---|
| Corn starch, carboxymethyl cellulose, ZnO nanoparticles | 0, 3, 5 wt.% | Higher concentrations of nano-ZnO (with 5 wt% ZnO) in the film increased the tensile strength, reduced the water vapor permeability, decreased the water solubility, and influenced the morphology, crystallinity, functional groups, and thermal stability of the films. | Packaging | Arifin et al. [123] |
| CeO2@starch | - | The maximum adsorption was done at pH = 2, and equilibrium was attained in 240 min of contact time. | Water treatment | Jaiyeola et al. [124] |
| ZnO/starch | 10%, 15%, 18%, and 20% w/w | Compared to the control sample (untreated fruits), ZnO/starch nanocomposite paper enhanced the shelf life of the fruits during incubation at 4 °C and resulted in fruits with acceptable quality. | packaging | Chitena et al. [125] |
| Materials | Method | Properties | Yield | Ref |
|---|---|---|---|---|
| Leftover celery pulp (Apium graveolens var. dulce) | Chemo-mechanical procedures including bleaching with NaClO2 and NaClO | Fibers with 100 to 150 μm, improvement in the mechanical and thermal stabilities for treated fibers | - | Abzan et al. [132] |
| Hardwood pulp | Ammonium persulfate oxidation | The surface charges: −33.6 mV to −44.5. Crystallinity indexes were 80.07 and 75.42 %. The lengths of the crystals were 157.31 ± 30.61 and 214.92 ± 65.52 nm. | 34–42% | Chen et al. [133] |
| Sugarcane bagasse | Autohydrolysis and alkaline sulfite hydrothermal approaches, followed by bleaching treatments, | Autohydrolysis at 170 °C for 1 h followed by a bleaching step was the treatment that presented the best results in terms of cellulose purity (77.8%), crystallinity (73.4%). | Autohydrolysis at 170 °C yielded 63.5% of a solid fraction with 69.4 ± 0.4% of cellulose, while alkaline sulfite at 180 °C yielded 50.9% of a solid fraction with 72.1 ± 5.8% cellulose. | Freixo et al. [134] |
| Materials | Filler | Properties | Application | Ref |
|---|---|---|---|---|
| ZnO/cellulose | 1 g of cellulose and 50 mL 0.2 M ZnCl2 | It had the highest photocatalytic activities for dye degradation owing to the strong electrostatic adsorption between carboxyl and ZnO as well as exposure of the interfacial active sites. | Photocatalyst | Shi et al. [136] |
| Cellulose/Fe3O4 | 1:1 ratio of cellulose and Fe3O4 | It showed high dye degradation efficiency (96.25%) at 120 min. | Photocatalyst | Arularasu et al. [137] |
| Cellulose-TiO2 | - | 100% removal of dye in 30 s under diverse temperatures and pH conditions. | Photocatalyst | Hong et al. [138] |
Disclaimer/Publisher’s Note: The statements, opinions and data contained in all publications are solely those of the individual author(s) and contributor(s) and not of MDPI and/or the editor(s). MDPI and/or the editor(s) disclaim responsibility for any injury to people or property resulting from any ideas, methods, instructions or products referred to in the content. |
© 2024 by the authors. Licensee MDPI, Basel, Switzerland. This article is an open access article distributed under the terms and conditions of the Creative Commons Attribution (CC BY) license (https://creativecommons.org/licenses/by/4.0/).
Share and Cite
Azadi, E.; Dinari, M.; Derakhshani, M.; Reid, K.R.; Karimi, B. Sources and Extraction of Biopolymers and Manufacturing of Bio-Based Nanocomposites for Different Applications. Molecules 2024, 29, 4406. https://doi.org/10.3390/molecules29184406
Azadi E, Dinari M, Derakhshani M, Reid KR, Karimi B. Sources and Extraction of Biopolymers and Manufacturing of Bio-Based Nanocomposites for Different Applications. Molecules. 2024; 29(18):4406. https://doi.org/10.3390/molecules29184406
Chicago/Turabian StyleAzadi, Elham, Mohammad Dinari, Maryam Derakhshani, Katelyn R. Reid, and Benson Karimi. 2024. "Sources and Extraction of Biopolymers and Manufacturing of Bio-Based Nanocomposites for Different Applications" Molecules 29, no. 18: 4406. https://doi.org/10.3390/molecules29184406
APA StyleAzadi, E., Dinari, M., Derakhshani, M., Reid, K. R., & Karimi, B. (2024). Sources and Extraction of Biopolymers and Manufacturing of Bio-Based Nanocomposites for Different Applications. Molecules, 29(18), 4406. https://doi.org/10.3390/molecules29184406

